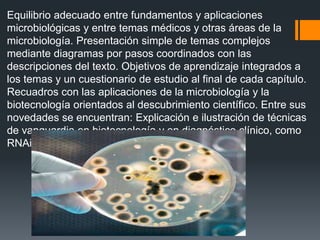
Equilibrio adecuado entre fundamentos y aplicaciones
microbiológicas y entre temas médicos y otras áreas de la
microbiología. Presentación simple de temas complejos
mediante diagramas por pasos coordinados con las
descripciones del texto. Objetivos de aprendizaje integrados a
los temas y un cuestionario de estudio al final de cada capítulo.
Recuadros con las aplicaciones de la microbiología y la
biotecnología orientados al descubrimiento científico. Entre sus
novedades se encuentran: Explicación e ilustración de técnicas
de vanguardia en biotecnología y en diagnóstico clínico, como
RNAi y FISH.

La novena edición de 'Introducción a la Microbiología' es un texto fundamental utilizado por más de un millón de estudiantes, que combina fundamentos y aplicaciones de la microbiología. Actualiza contenidos sobre emergencias de enfermedades, biotecnología y antimicrobianos, integrando recursos didácticos que fomentan el aprendizaje. A través de sus secciones, aborda la importancia de los microorganismos en la salud, el medio ambiente y la industria alimentaria.